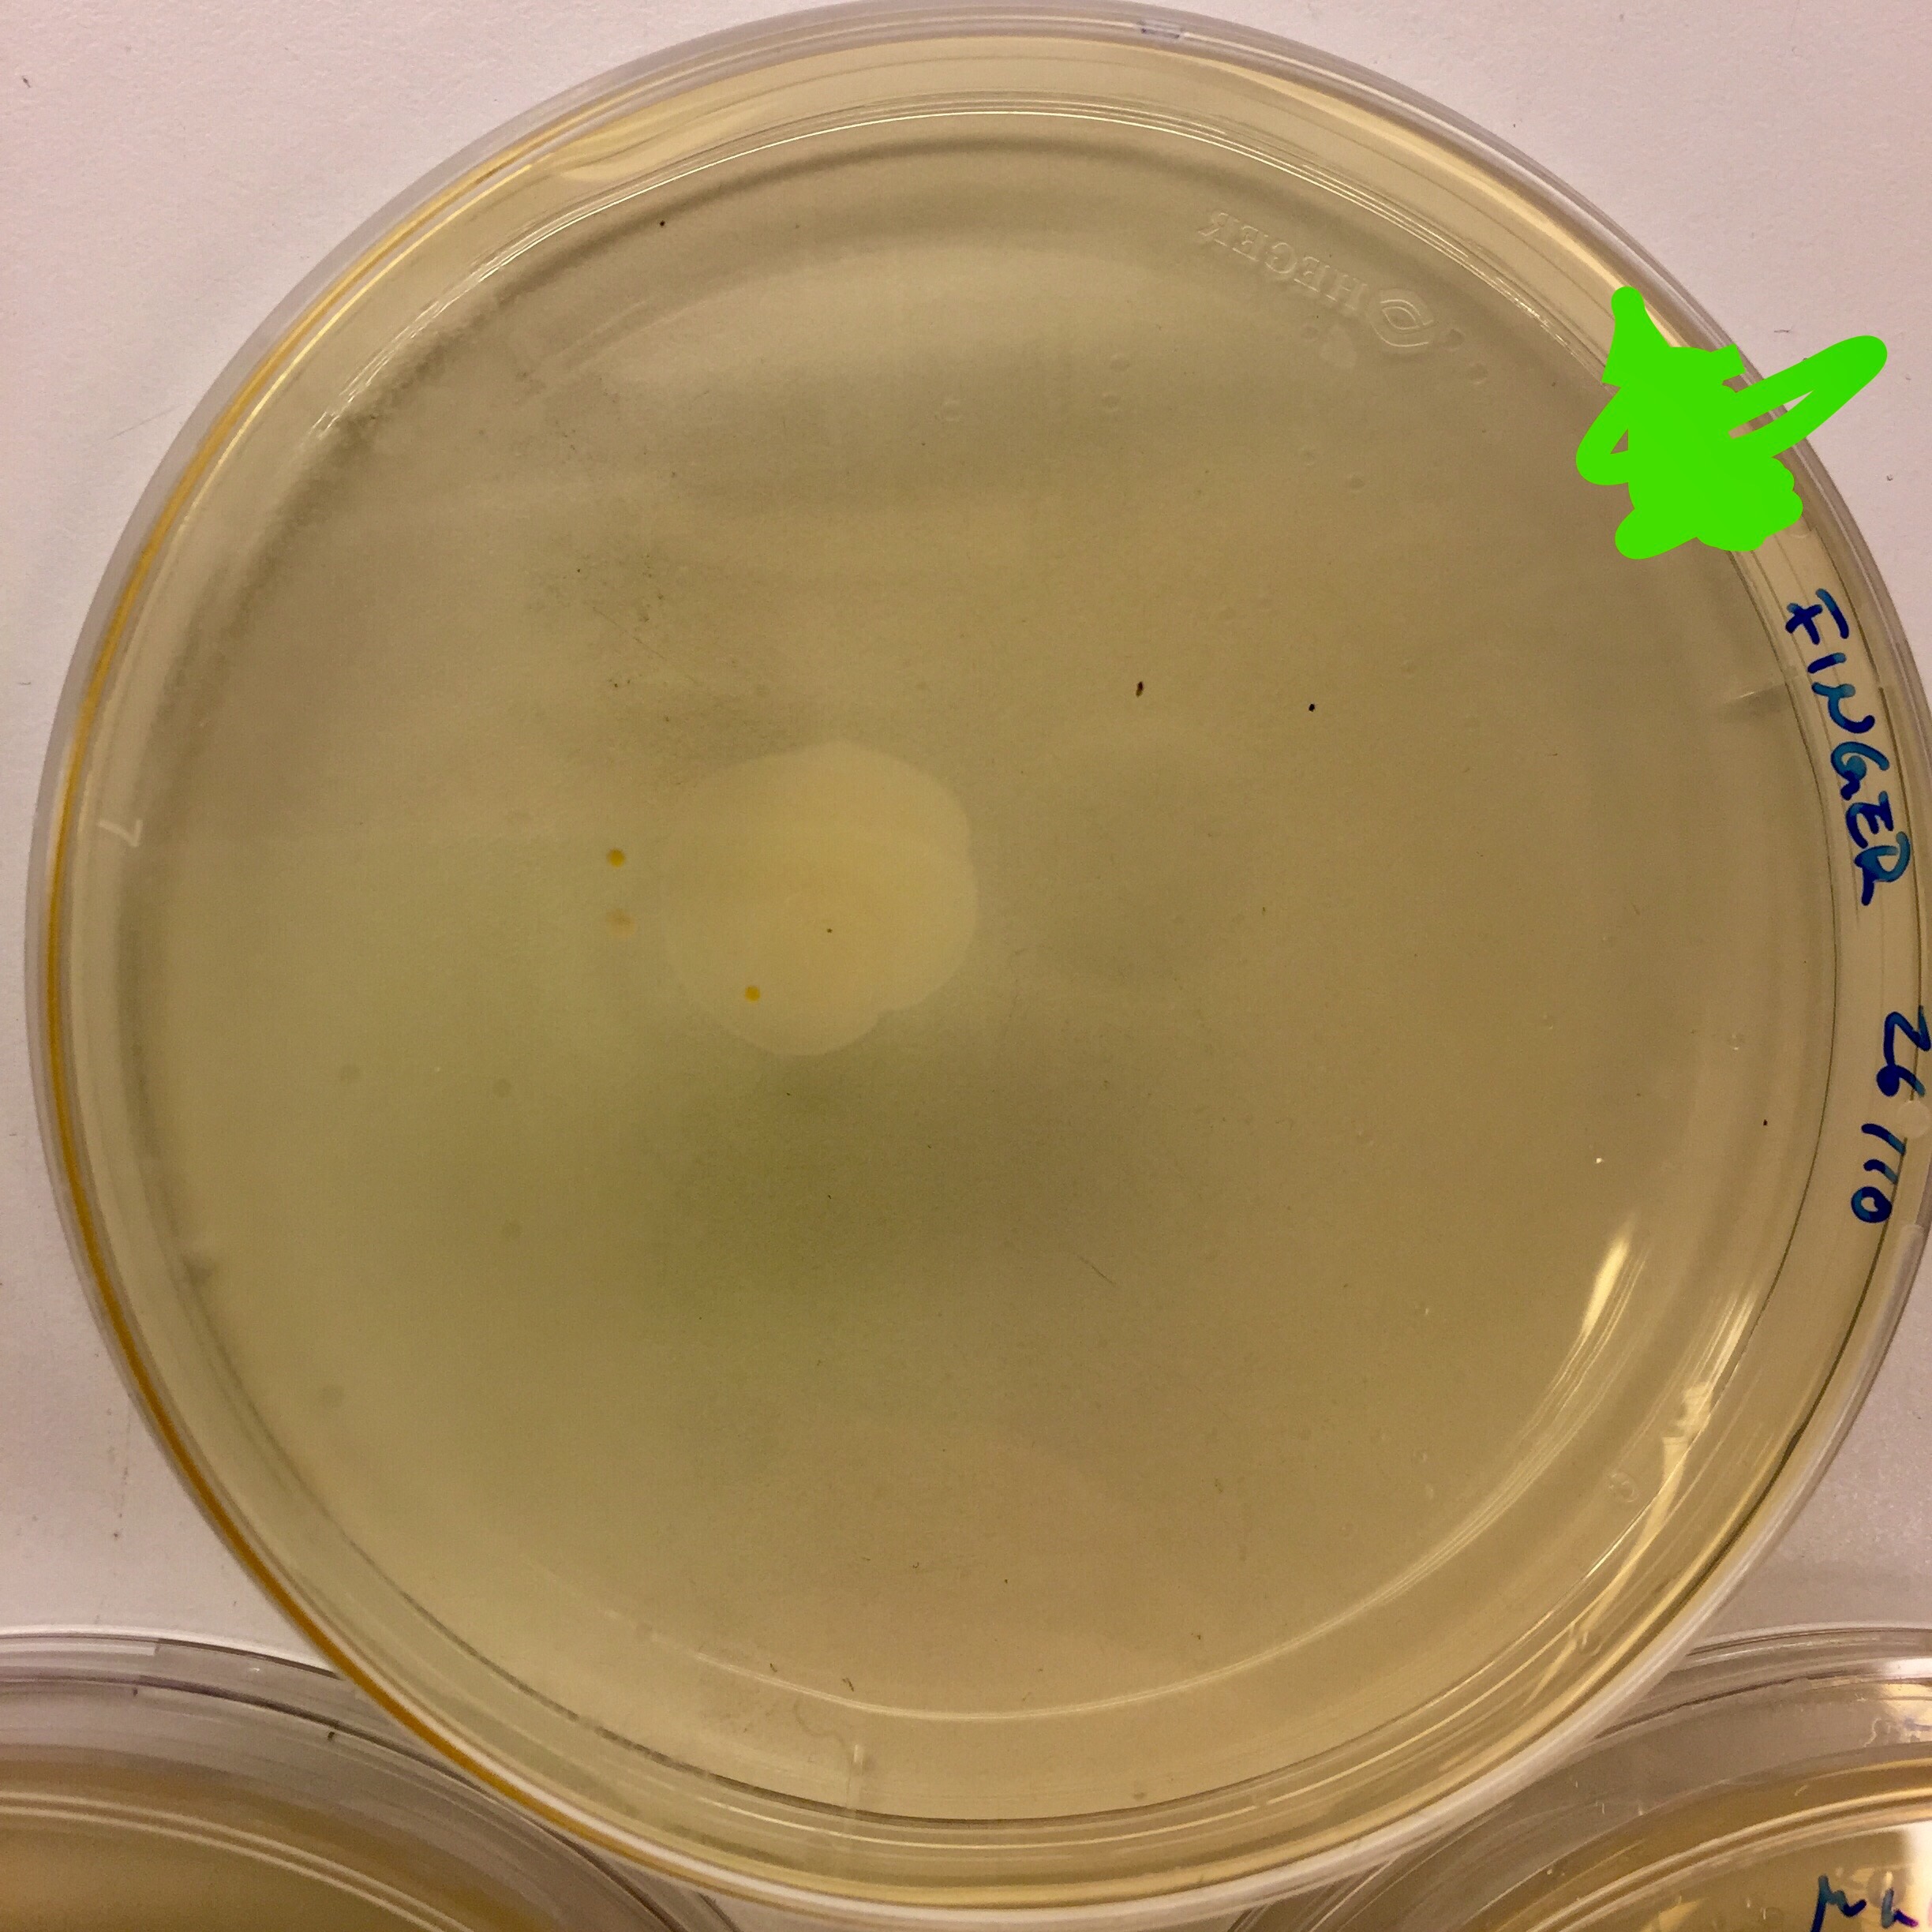
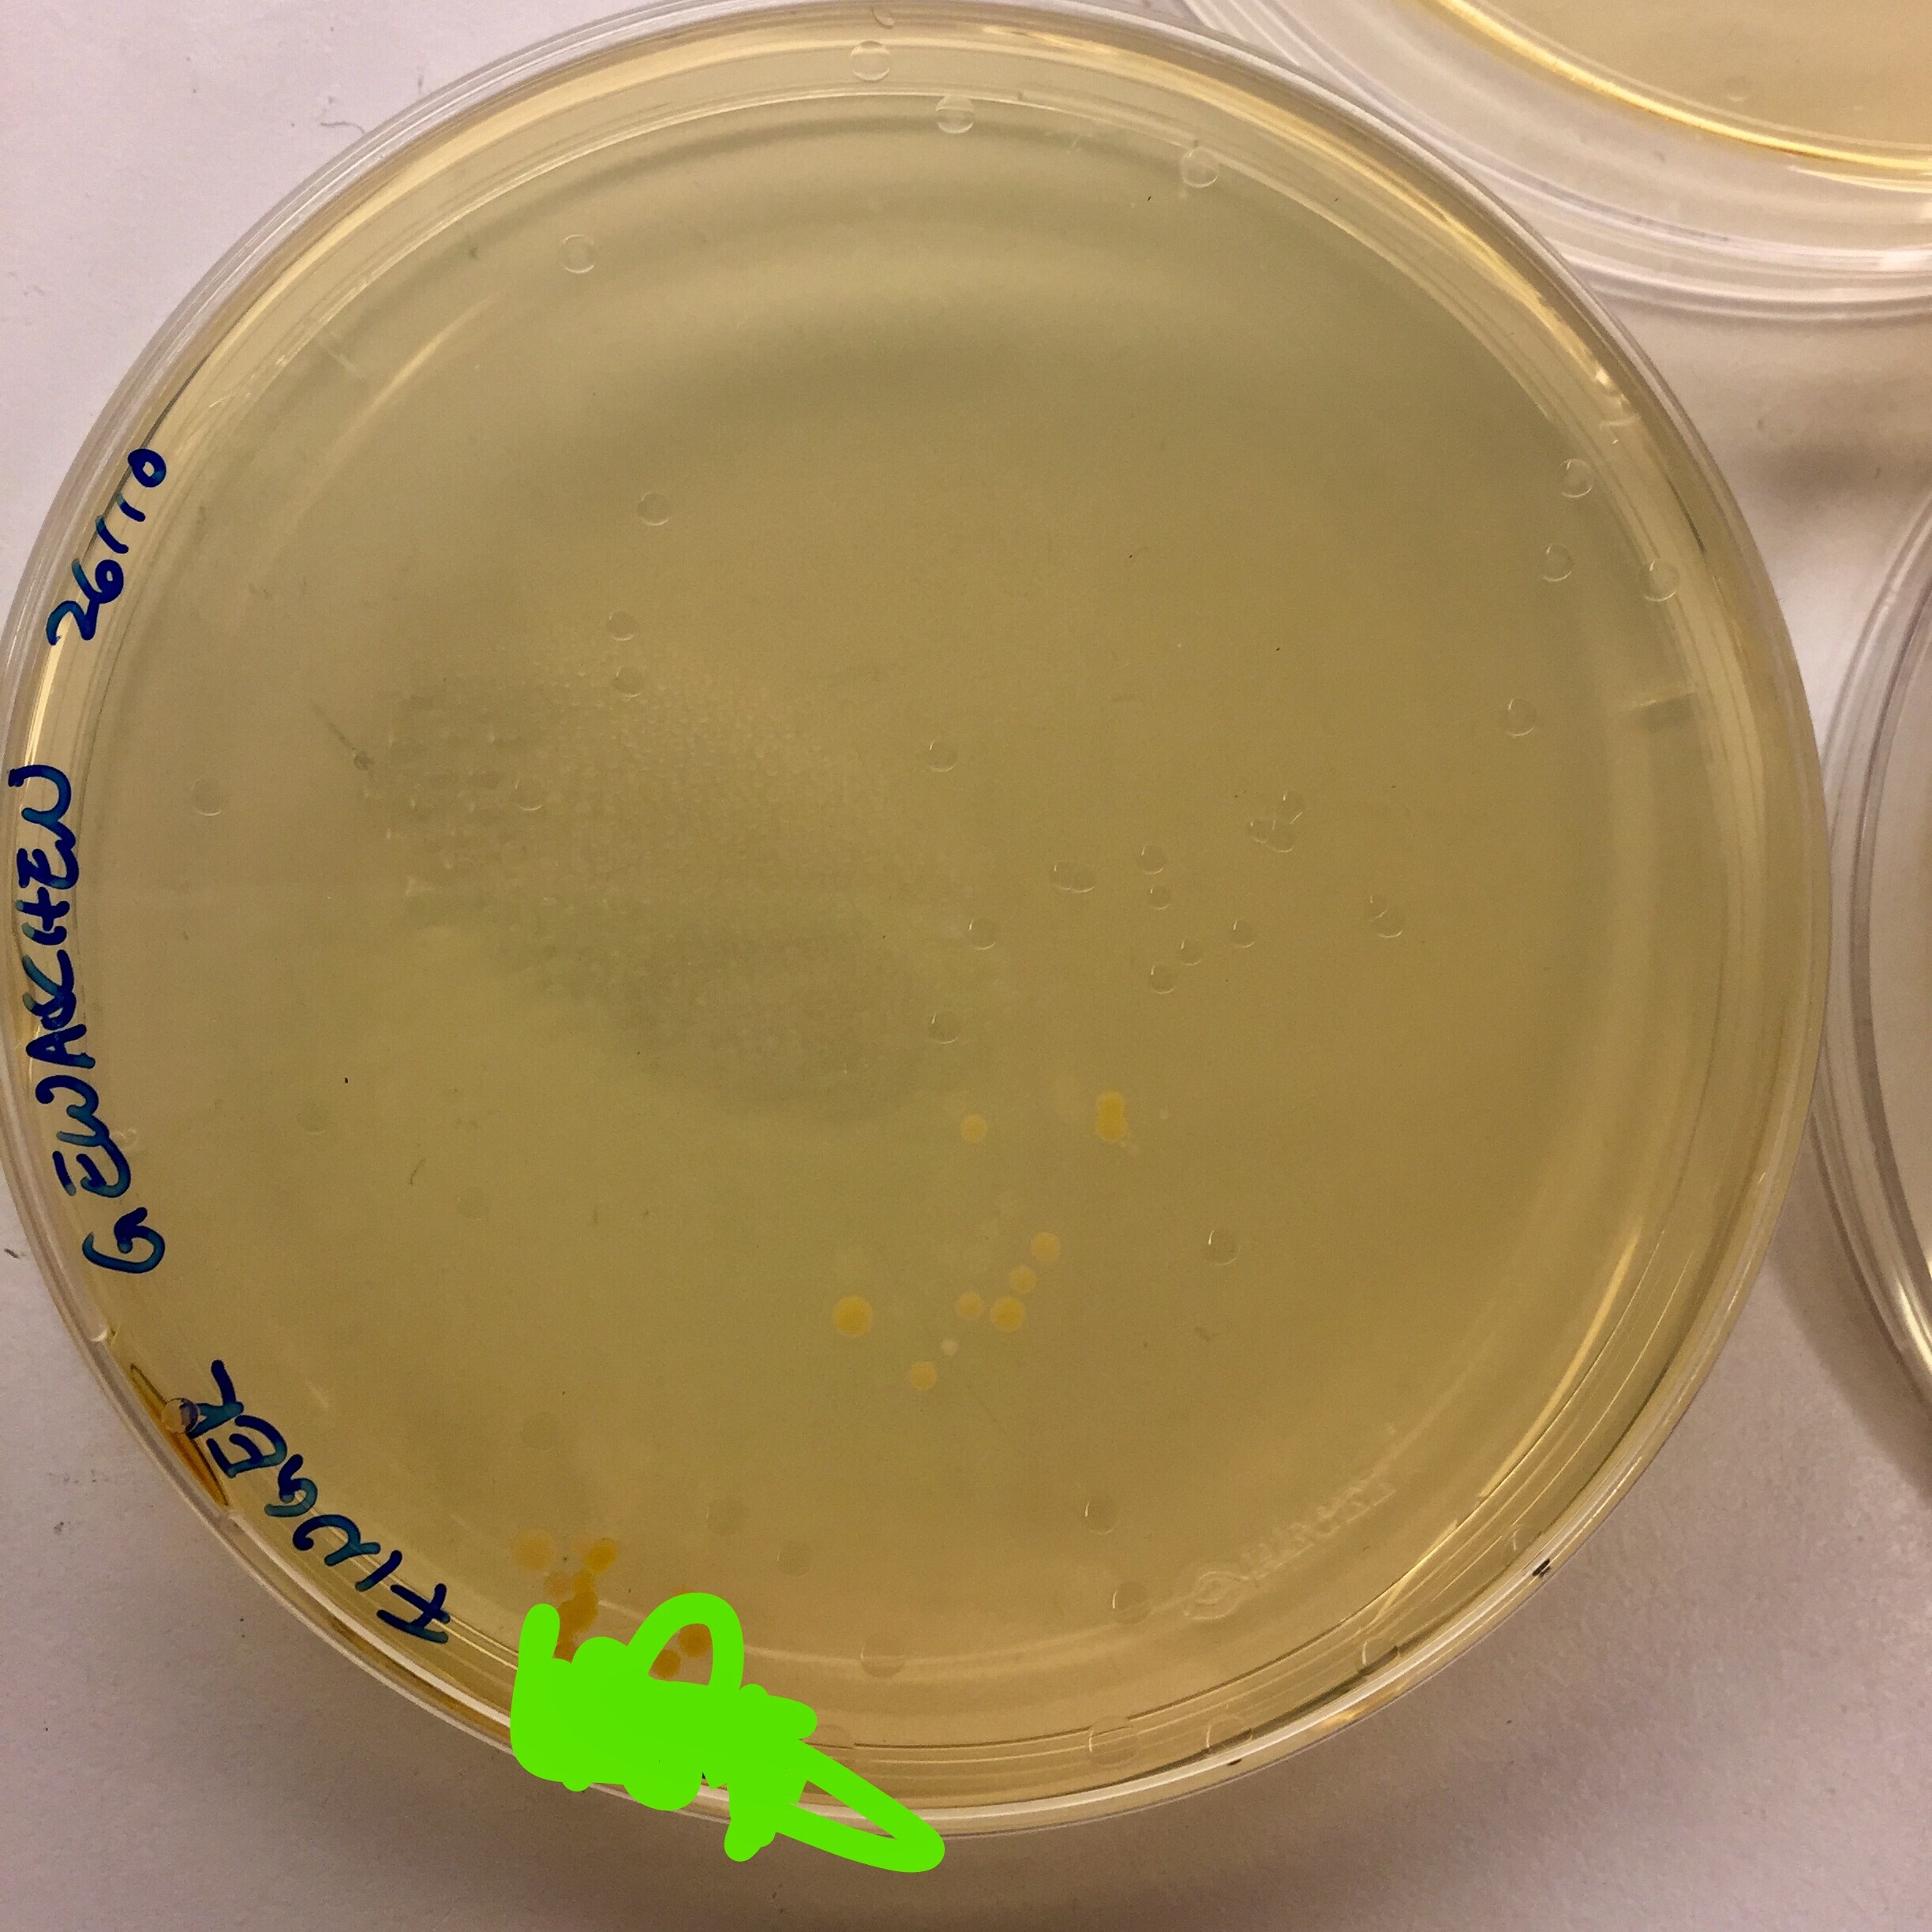
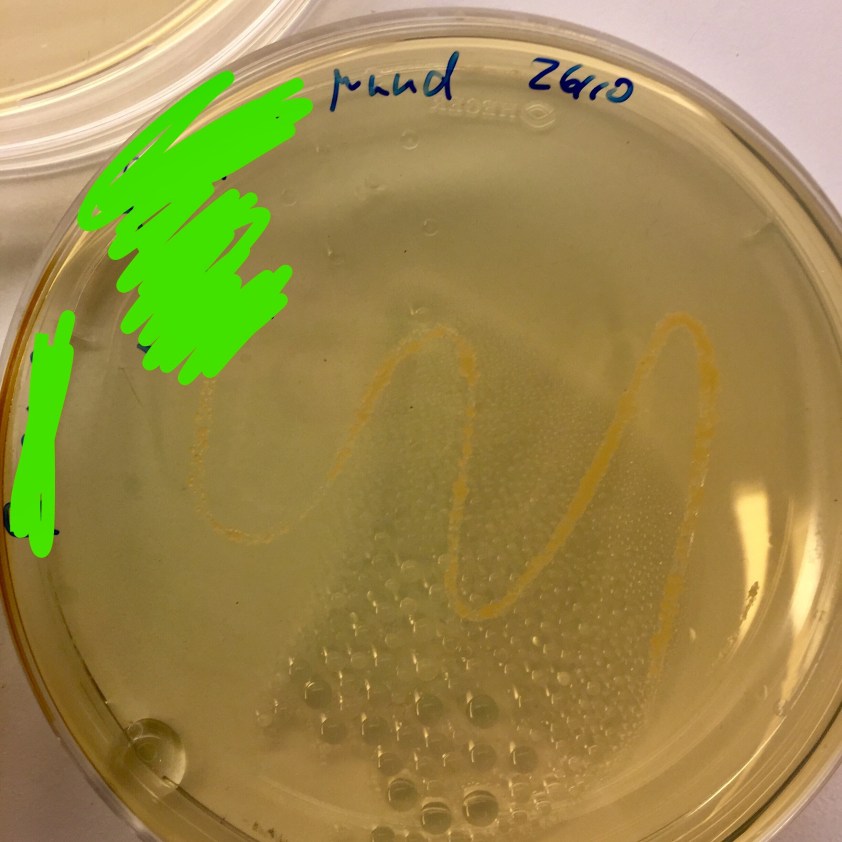

Neulich rief ich ja zum Fragen stellen auf. Es gab zwei:
1. Warum wachsen die Austernpilze im Kühlschrank?
Das ist ein Misverständnis. Ich habe nur den Rest der Kultur, also des Mycels, in den Kühlschrank gestellt, weil das ja nicht weiter wachsen soll. Die echten Kulturen, von denen ich später ernten möchte, stehen dunkel aber warm, im Küchenschrank. So simuliert man quasi Sommer. Nach ein paar Wochen dann werde ich Herbst simulieren, indem ich die Kulturen wässere („Regenguss“) und eine Nacht lang kühl stelle, vermutlich in den Flur (6-15 Grad sind optimal). Dann werden auch Löcher in den Eimer bzw. die Tüte geschnitten, aus denen die Pilze wachsen können. Je nach Temperatur im Flur werde ich sie dann entweder da lassen oder ins Schlafzimmer umsiedeln: die Pilze wachsen am besten bei 10-17 Grad und bei Tageslicht. Die Infos hab ich alle von Hier. Bisher sieht es bis auf den Flausch auf den Kulturen ganz gut aus und der Geruch ist der gleiche würzige wie als ich das Mycel auspackte, also: wird schon schief gehen.
(Vielleicht noch als Ergänzung: ich habe die Pilze nicht im Keller weil es da tendenziell zu kalt ist und auch zu feucht. Eigentlich ist es sogar für das Feuerholz zu feucht da, aber was will man machen, wir können ja nicht mal eben zwei Kubikmeter Holz in der Wohnung lagern.)
2. Warum nehmen wir kein Tran mehr?
Weil Tran mega eklig ist. Selbst wenn es total viel besser wäre als reines Vitamin D, ist es bei uns da – trotz aller Bemühungen – nicht so sonderlich weit her mit der Compliance. Und dann bringt es doch viel mehr, wenn wir Großen täglich so ne Kapsel einwerfen, Pippi kriegt Tropfen (auf die Zahnbürste, die lutscht sie nämlich zuverlässig ab) und Michel seine heiß geliebten „Sonnentabletten“, nämlich Vitamin D Kautabletten für Kinder von dm. Und warum von dm und nicht von hier ist einfach dem Preisunterschied geschuldet. Hier kosten Nahrungsergänzungsmittel wirklich unfassbar viel Geld. Keine Ahnung warum. Aber hier bezahlt man für 100 Vitamin D Tabletten ca. 100 Kronen, also im Moment ca. 9 €. In Deutschland kosten 60 Stück 2,65 €. Und da der dm-Großeinkauf ja eh jedes Mal auf dem Plan steht, werden da halt jetzt auch Vitamin-D-Tabletten gekauft.
(3. Keine echte Frage und auch eigentlich gar nicht dazu passend aber neulich wurde ich auch gefragt, ob das mit der linken Augenbraue wohl Erbmasse sei. Auf jeden Fall! Ich kann nur beide, oder links. Gibt es überhaupt Menschen die beide Augenbrauen getrennt voneinander hochziehen können? o.O)